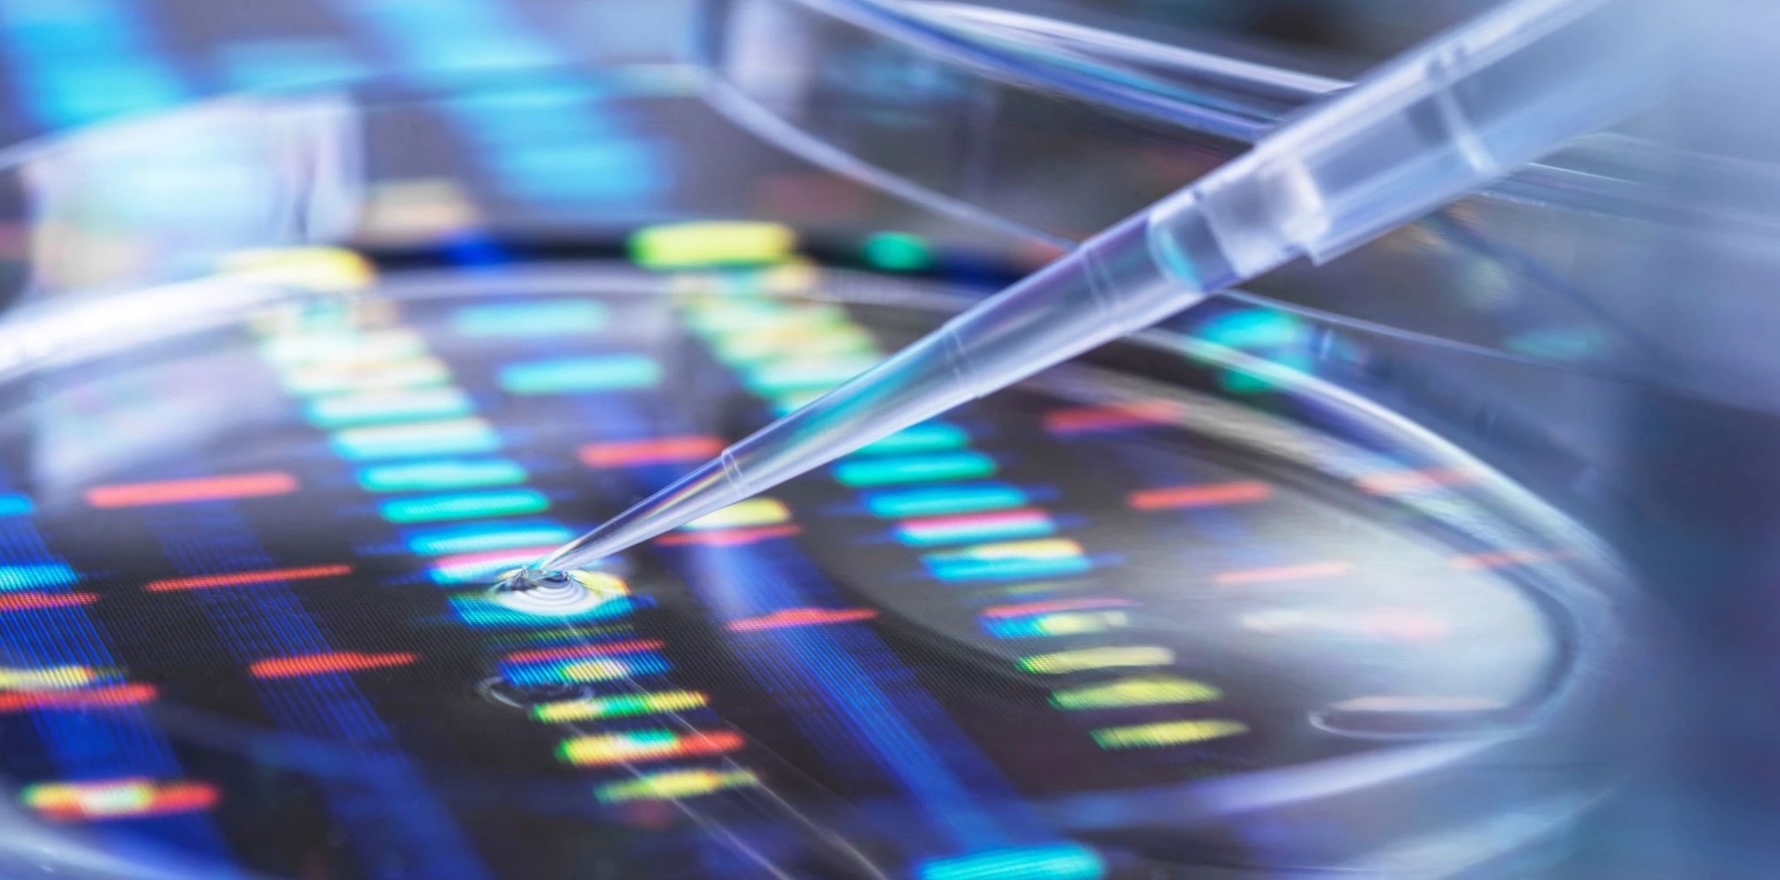

Life insurers will be banned from using genetic testing results to exclude people from coverage if passed, and NDIS providers who injure or kill patients will face much stiffer penalties.
Life insurers will be banned from using genetic testing results to exclude people from coverage if passed, and NDIS providers who injure or kill patients will face much stiffer penalties.